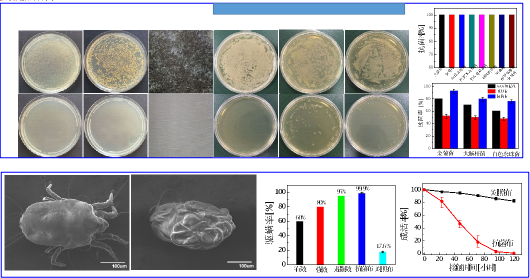

成果简介(300-500字)
海思美域(深圳)科技有限公司是由一批高学历、高职称和经验丰富的创新型专业人才组成。本技术成果来源于深圳大学,前期投入研发1000万元,得到了国家自然科学基金、广东省科技计划项目和深圳市科技计划项目、南山区创新平台及深圳大学交叉科研团队项目等科研项目的大力支持,。团队经过15年的深耕,已掌握本领域的核心技术,开发了系列持久抗菌抗病毒除螨技术,已获得广东省科技进步二等奖2项和广东省优秀科技成果1项。
基于自主研发的抗菌防霉、抗病毒和除螨整理剂,采用低温节能的先进整理工艺,以共价键结合到纺织品(棉纺织品、羊毛、丝、尼龙、涤纶、丙纶等),在不负面影响纺织品本身的理化性质的基础上,赋予纺织品高效、持久、广谱抗菌防霉、抗病毒和除螨等多功能。并可精确调控其抗菌防霉、抗病毒、除螨和细菌粘附性,以满足人们对不同应用场景的需求。与国内外同类技术相比,本技术所得多功能纺织品兼有高效、持久、广谱抗菌防霉、抗病毒和除螨功能,附着力更强、无溶出、无毒无皮肤刺激性,不负面影响纺织品的力学性能、透湿透气性、柔软度、白度(色差)等优点。
图1整理后纺织品的广谱、高效、持久的抗菌、防霉和除螨活性

图2本技术的抗菌抗病毒和毒理性第三方评估报告
技术创新
抗菌除臭、抗病毒和除螨多功能纺织面料改性化。
专利情况
授权美国发明专利:US8623843B2, US10368544B2, US10609927B2,
US11044908B2、 US11252954B2
授权中国发明专利:ZL201010106007.3,ZL201010116533.8,ZL201210377540.2,
ZL201580001138.6,ZL201580001140.3,ZL201810096512.0,
ZL201710400759.2,ZL201910181723.9
市场前景及应用领域
可广泛应用纺织业、大健康、服务业、食品业及日常生活等,赋予产品抗菌除臭、抗病毒和除螨纺织品。
合作方式:技术许可使用、股权投资、合作创办企业等技术合作方式,提供从项目策划至项目运行全套技术服务。
成果单位:海思美域(深圳)科技有限公司
成果负责人:陈仕国
联系电话:13826542730
电子邮箱:csg@szu.edu.cn